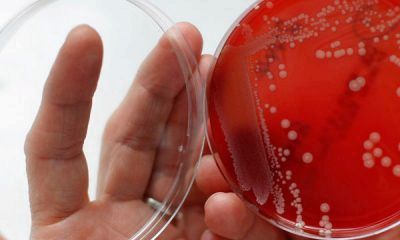

Що стосується чоловіків, то основні причини зараження криються в незахищеному статевому контакті, внаслідок якого і відбувається проникнення шкідливих мікроорганізмів.
Основний шлях проникнення гарднерели - сечовивідні канали.
Варто нагадати про те, що проникнення бактерій в чоловічий організм далеко не завжди закінчується зараженням і бурхливим розвитком захворювання. Сечовивідні канали у сильної статі облаштовані таким чином, що шкідливі збудники інфекційного захворювання вже на 3 добу виводяться з чоловічого організму, не завдаючи йому ніякої шкоди. Однак якщо складаються не зовсім сприятливі умови, в число яких входять переохолодження організму, зниження його захисних сил, активування будь-яких хронічних хвороб, то інфекційний агент починає рости і розмножуватися. Бурхлива життєдіяльність патогенних мікроорганізмів обов'язково призводить до запалення слизової оболонки уретри.
Таким чином, основний шлях зараження - статевий контакт із зараженою жінкою. Рідше інфікування відбувається через предмети побуту. Наприклад, дуже висока ймовірність зараження гарднереллой шляхом користування загальним рушником.
Гарднерелла вагіналіс - захворювання, яке деколи може носити прихований характер. Заражений чоловік може дуже довгий час не здогадуватися про хворобу, так як дуже часто вона ніяким чином себе не проявляє. Ніяких симптомів при наявності інфекції в організмі не спостерігається, але основна проблема криється в тому, що чоловік є носієм і, що найнебезпечніше, рознощиком захворювання.
У деяких же представників сильної половини людства все ж виявляються основні ознаки, за якими можна судити про наявність хвороби. Ці ознаки в більшості випадків чоловік відзначає у себе вже після першого тижня інфікування. Зовні це виглядає як слабо проявлений запальний процес на голівці пеніса.
У деяких випадках на такі симптоми чоловік і зовсім не звертає уваги, проте ігнорування такої ситуації загрожує дуже серйозними наслідками для чоловічого здоров'я. Ситуація ускладнюється тим, що з часом з головки починає активно виділятися неприємно пахне рідина зеленуватого відтінку. Крім цього, чоловік починає скаржитися на дуже сильний біль і печіння в процесі сечовипускання.

Слід нагадати, що подібними симптомами проявляється таке захворювання, як уреплазма, тому нерідко їх плутають між собою.
Отже, гарднерельоз у чоловіків проявляється наступними ознаками:
- незвичайні виділення,
- виділення мають неприємний запах, іноді нагадує запах протухлої риби,
- нерідко спостерігаються висипання на чоловічих статевих органах,
- на голівці пеніса з часом проявляється потемніння.
Якщо чоловік починає помічати у себе присутність хоча б одного з перерахованих вище клінічних проявів, необхідно терміновим чином проконсультуватися з відповідним фахівцем, щоб не дати можливості інфекції розвинутися. Адже якщо не розпочати лікування гарднереллеза у чоловіків, то захворювання може привести до таких хвороб, як:
При виникненні циститу у чоловіка проступає така ознака, як сильне болюче відчуття під час сечовипускання. При пієлонефриті відчуваються болі в м'язах і з'являється лихоманка. Епідідіміт дає про себе знати болем в області яєчка, попереку, паху і крижів.

Хоча ймовірність розвитку цих захворювань не дуже висока, але все ж таке може статися. Тому звернутися до лікаря варто негайно. Тільки лише досвідчений фахівець зможе поставити правильний діагноз і призначити адекватне та ефективне лікування.

Так як гарднерельоз у чоловіків має деяку схожість з іншими інфекційними хворобами, то перш ніж приступати до лікування, чоловікові потрібно пройти етапи діагностування. А для цього хворому, що має підозри на наявність у себе гарднереллеза, потрібно звернутися зі своєю проблемою до дерматовенеролога, венеролога або уролога.

Для постанови правильного діагнозу лікар направить хворого на здачу мазка з уретри. Саме з цього аналізу проводять полімеразно-ланцюгову реакцію. Завдяки цьому високоефективному методу і виявляють наявність гарднерел.
Діагностування хвороби не буде потрібно, якщо це захворювання було виявлено у статевої партнерки чоловіки. В цьому випадку проходження всіх етапів діагностування буде просто недоцільним. Повний курс лікування повинні пройти обидва партнера, після якого ними здається контрольний аналіз і з його допомогою визначається наявність гарднерел в організмі.
Крім того, чоловік, у якого було виявлено гарднерельоз, повинен пройти повне обстеження на наявність у нього інших венеричних хвороб, так як деякі захворювання проникають в організм разом з гарднереллой.

Методи терапії
Як вже було зазначено раніше, у деяких представників сильної статі гарднерельоз не має яскраво вираженої клінічної картини. Однак і в цьому випадку гарднерельоз у чоловіків вимагає невідкладної терапії, так як її носій являє дуже серйозну небезпеку для своїх статевих партнерок. Чоловікові необхідно пройти повне обстеження свого організму в разі виявлення у нього додаткових запальних процесів. Не зайвим буде перевірити і стан його імунної системи.
По термінах лікування гарднерельоз займає близько 2-х тижнів.

Схема лікування гарднереллеза у чоловіків передбачає не тільки прийом потрібних і результативних медичних засобів, але і дотримання деяких важливих правил, а саме:
- повна відмова від сексуальних відносин,
- утримання від вживання копчених, гострих і пряних продуктів харчування,
- уникнення прямих сонячних променів,
- заборона алкогольних напоїв, навіть пива,
- відсутність фізичної напруги,
- відмова від походів в сауну або лазню,
- відсутність стресів, переживань і хвилювань.
Найчастіше, всім чоловікам, які зіткнулися з гарднереллезом, лікар призначає місцеве лікування. Пов'язано це, перш за все, з тим, що оральний прийом медпрепаратів часто призводить до небажаних побічних ефектів. Найбільш продуктивними препаратами на цей випадок є:
В основу всіх цих медичних препаратів входить активне антибактеріальну речовину, здатну в найкоротші терміни ліквідувати інфекцію.
Якщо після отримання місцевої терапії не відзначаються ніякої позитивної динаміки або гарднерельоз привів до виникнення ускладнень, тоді основний курс лікування буде спрямований на прийом антибіотиків. Ні в якому разі не можна приймати ці препарати без відома лікаря. Саме розбирається в цій нелегкій справі фахівець повинен призначити необхідні ліки. А зробити це він повинен тільки після того, як визначить реакцію збудника захворювання на антибактеріальні засоби. Тут враховуються також можливі побічні реакції організму хворого.
Так як курс антибіотиків, як правило, викликає дисбактеріоз кишечника, хворому разом з ними призначаються пробіотики, необхідні для налагодження роботи цього важливого органу.

Під час лікування особливу увагу слід приділити загальному стану організму, а саме станом імунної системи. Для підтримки організму призначаються комплекси вітамінів і мінералів, а також не зайвим виявиться прийом загальнозміцнюючих засобів і біостимуляторів. У разі зниження імунітету хворому призначаються імуномодулятори.
Таким чином, схема лікування гарднереллеза передбачає прийом таких препаратів:
- антибіотики широкого спектру дії,
- антибіотики ряду тетрацикліну,
- препарати імуномодулятори для противірусного і протизапального впливу,
- антисептичні засоби для місцевого застосування,
- ферменти для врегулювання "ситуації" в кишечнику,
- обов'язкове вживання вітамінів.
Припиняти курс лікування чоловік повинен тільки за призначенням лікаря. Зникнення симптомів хвороби зовсім не означає відступ захворювання. Лікар повинен провести ряд аналізів на стан мікрофлори і робиться це кілька разів для виявлення можливих рецидивів.
Для запобігання такої хвороби, як гарднерельоз, потрібне дотримання профілактичних заходів. Профілактика цього захворювання передбачає, перш за все, не ігнорування простих гігієнічних правил. Дуже важливо, щоб у чоловіка була постійна партнерка, якої він зміг би довіряти. У разі ж непостійності, важливо завжди мати при собі надійну контрацепцію, але навіть вона не дає стовідсоткової гарантії.

У разі найменшого прояву симптомів захворювання, найнадійніший спосіб захистити себе від серйозних ускладнень - це здійснити візит до лікаря.
Кожному чоловікові необхідно пам'ятати про те, що на сьогодні існує чимало клінік урологічного напрямки. І всі вони можуть провести якісну діагностику гарднереллеза навіть при його безсимптомному перебігу. А лікування вони проводять за допомогою найсучасніших медичних препаратів. Звернувшись в подібне медичний заклад, можна гарантовано уникнути можливих небажаних наслідків.
Отже, основні профілактичні заходи включають в себе:
- при виявленні у своєї партнерки навіть найменших гінекологічних розладів, необхідно переконати її в неефективності самолікування і відразу ж направити її до лікаря,
- при наявності у статевої партнерки гарднереллеза, зараження чоловіка може і не відбутися, однак пройти обстеження все ж рекомендується,
- дуже важливо дотримуватися всі основні правила лікування хвороби, так як нерідко разом з гарднереллезом у чоловіків виявляються і інші не менш серйозні захворювання, що вимагають негайної реакції і адекватного лікування,
- приступати до повноцінного сексуального життя можна тільки після повного позбавлення від хвороби,
- обов'язково дотримуватися елементарних правил гігієни, тобто регулярно митися і міняти нижню білизну.
Причини і лікування гарднерели у чоловіків
Будь-яке статеве інфекційне захворювання, в тому числі і гарднерельоз, необхідно лікувати після консультації з лікарем.
Самолікування в даному випадку може закінчитися отриманням самих негативних результатів і наслідків для чоловічого здоров'я, аж до порушення репродуктивної функції. Щоб уникнути таких плачевних результатів чоловікові, що запідозрив у себе наявність гарднереллеза, варто негайно бігти до лікаря для того, щоб останній поставив правильний діагноз і призначив швидке продуктивне лікування. Своєчасна допомога кваліфікованого фахівця допоможе підібрати правильні медичні препарати і вже незабаром чоловік зможе знову насолоджуватися повноцінним і якісним життям.
Хто сказав, що вилікувати венеричні захворювання важко?
- Невероятно- Можна вилікувати сифіліс, гонорею, мікоплазмоз, трихомоніаз та інші венеричні захворювання назавжди!
- Це по-перше.
- Без прийому антибіотиків!
- Це два.
- За тиждень!
- Це три.
Ефективний засіб існує. Перейдіть по посиланню і дізнайтеся що рекомендує венеролог Сергій Бубновський!